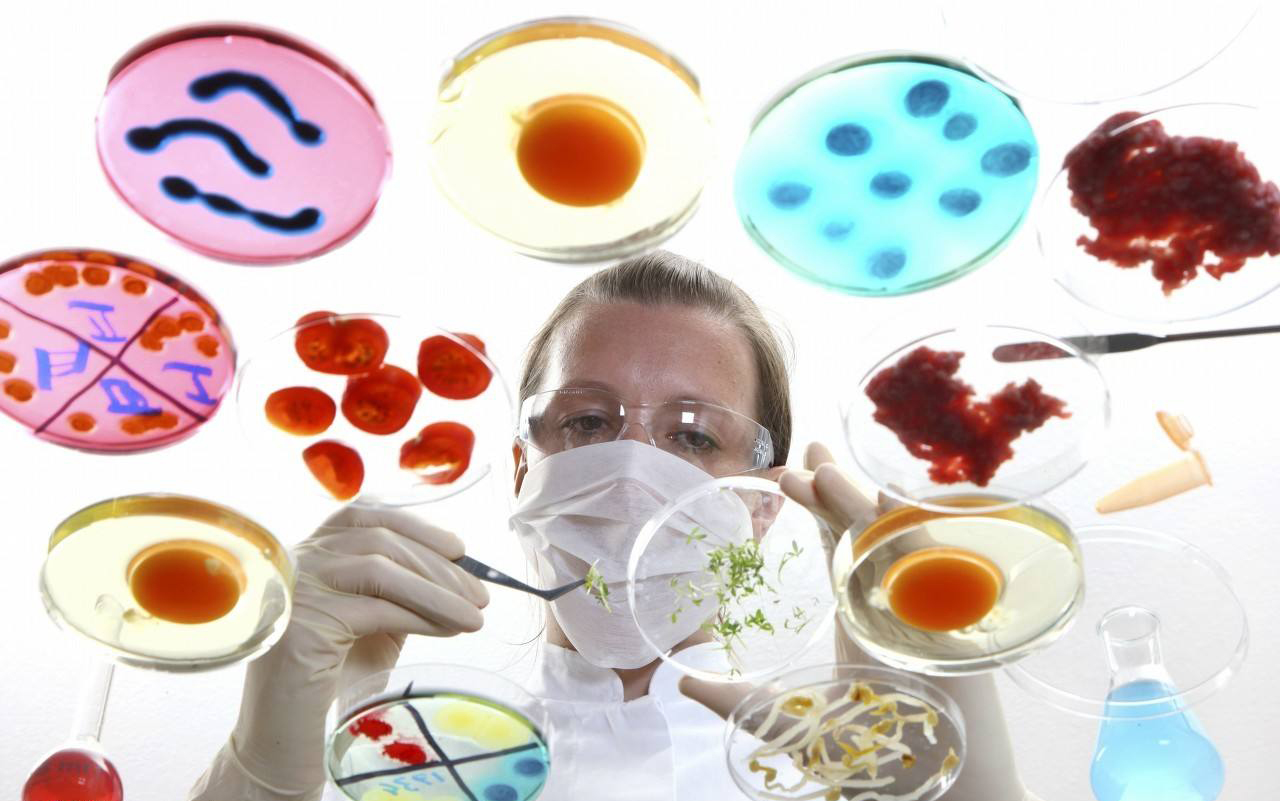
留学新西兰大学奖学金

最新信息:恭喜育才外国语欧美部Z同学获取剑桥大学面试 Oct 02, 2021... 阅读更多信息
X
R
O
A
D
S
E
D
U
- 中国辽宁·沈阳
- help@roadsedu.com
- Mon _ Sat: 9.00 to 18.00